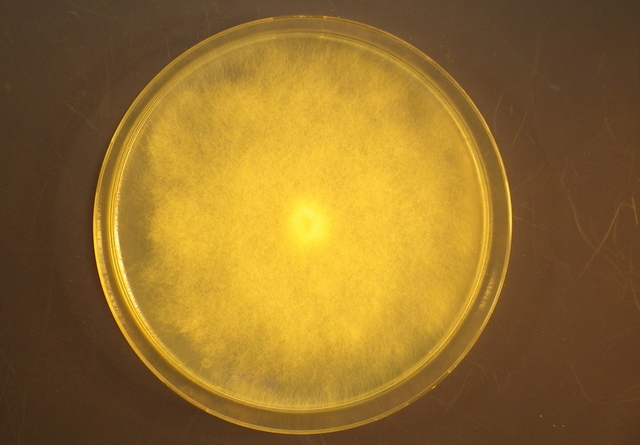
Grow P.ultimum on Malt Agar
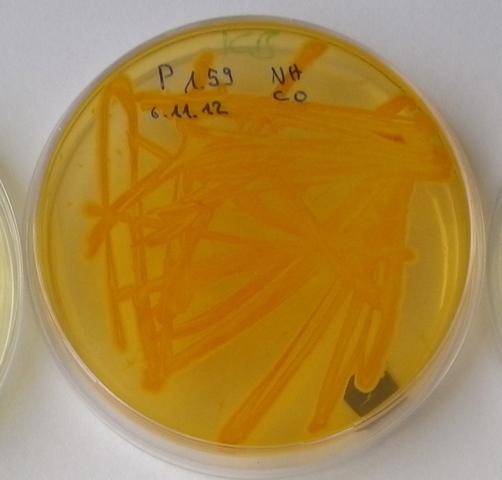
Grow biocontrol bacteria on agar plates

-
-
-
-
-
-
-
add pathogen to the soil, plant 3 pregerminated cucumber seedlings per pot and water pots with bacteria or control as well as with water
-
-
-
-
-
-
assessing seedlings for survival/ scoring/ fresh weight
Plan projects on a visual timeline
Map milestones, phases, deadlines, and key events in one place so the sequence is easier to see and share. Timetoast is a timeline maker for work, school, research, and stories.